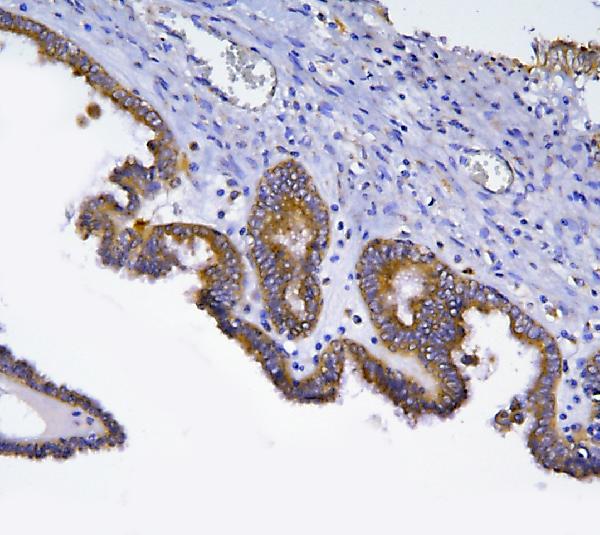
Figure 2. IHC analysis of HOOK2 using anti-HOOK2 antibody (A08854-1). HOOK2 was detected in a paraffin-embedded section of human ovarian cancer tissue. Heat mediated antigen retrieval was performed in EDTA buffer (pH 8.0, epitope retrieval solution). The tissue section was blocked with 10% goat serum. The tissue section was then incubated with 2 microg/ml rabbit anti-HOOK2 Antibody (A08854-1) overnight at 4°C. Peroxidase Conjugated Goat Anti-rabbit IgG was used as secondary antibody and incubated for 30 minutes at 37°C. The tissue section was developed using HRP Conjugated Rabbit IgG Super Vision Assay Kit (Catalog # SV0002) with DAB as the chromogen.

Figure 1. Western blot analysis of HOOK2 using anti-HOOK2 antibody (A08854-1). Electrophoresis was performed on a 5-20% SDS-PAGE gel at 70V (Stacking gel) / 90V (Resolving gel) for 2-3 hours. The sample well of each lane was loaded with 30 ug of sample under reducing conditions. Lane 1: human RT4 whole cell lysates, Lane 2: human MCF-7 whole cell lysates. After electrophoresis, proteins were transferred to a nitrocellulose membrane at 150 mA for 50-90 minutes. Blocked the membrane with 5% non-fat milk/TBS for 1.5 hour at RT. The membrane was incubated with rabbit anti-HOOK2 antigen affinity purified polyclonal antibody (Catalog # A08854-1) at 0.5 microg/mL overnight at 4°C, then washed with TBS-0.1%Tween 3 times with 5 minutes each and probed with a goat anti-rabbit IgG-HRP secondary antibody at a dilution of 1:5000 for 1.5 hour at RT. The signal is developed using an Enhanced Chemiluminescent detection (ECL) kit (Catalog # EK1002) with Tanon 5200 system. A specific band was detected for HOOK2 at approximately 83 kDa. The expected band size for HOOK2 is at 83 kDa.
Anti-HOOK2 Antibody Picoband(r)
A08854-1-CARRIER-FREE
ApplicationsFlow Cytometry, ImmunoFluorescence, Western Blot, ELISA, ImmunoCytoChemistry, ImmunoHistoChemistry
Product group Antibodies
ReactivityHuman
TargetHOOK2
Overview
- SupplierBoster Bio
- Product NameAnti-HOOK2 Antibody Picoband(r)
- Delivery Days Customer9
- ApplicationsFlow Cytometry, ImmunoFluorescence, Western Blot, ELISA, ImmunoCytoChemistry, ImmunoHistoChemistry
- CertificationResearch Use Only
- ClonalityPolyclonal
- Concentration500 ug/ml
- Gene ID29911
- Target nameHOOK2
- Target descriptionhook microtubule tethering protein 2
- Target synonymsHK2, protein Hook homolog 2, h-hook2, hHK2, hook homolog 2
- HostRabbit
- IsotypeIgG
- Protein IDQ96ED9
- Protein NameProtein Hook homolog 2
- Scientific DescriptionBoster Bio Anti-HOOK2 Antibody Picoband® catalog # A08854-1. Tested in ELISA, Flow Cytometry, IF, IHC, ICC, WB applications. This antibody reacts with Human. The brand Picoband indicates this is a premium antibody that guarantees superior quality, high affinity, and strong signals with minimal background in Western blot applications. Only our best-performing antibodies are designated as Picoband, ensuring unmatched performance.
- ReactivityHuman
- Storage Instruction-20°C,2°C to 8°C
- UNSPSC12352203